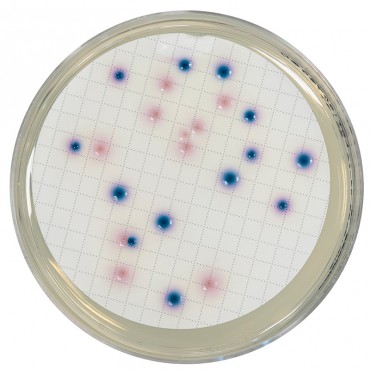

- +Produits
- +Consommables de laboratoire
- +Équipement de laboratoire
- +Équipement pour la microbiologie
- +Milieux de Culture - réactifs et trousses de performance
- +Solutions de sécurité alimentaire Neogen®
- +Systèmes de surveillance des températures et de l'humidité
- +Tests d'allergènes
- +Tests environnementaux
- +Services
- SUPPORT
- Nouvelles
- +À propos de nous
- Contact






Compass CC pour E.coli & coliformes
COMPASS® cc Agar permet d’effectuer le dénombrement des Escherichia coli et des bactéries coliformes dans les eaux par la méthode de filtration sur membrane dès 21 heures d’incubation et sans étape supplémentaire de confirmation par les tests de recherche de l’oxydase ou de révélation de la production d’indole à partir du tryptophane. COMPASS® cc Agar est adapté aussi bien au contrôle des eaux désinfectées et des autres eaux potables ne comprenant qu’un faible nombre de bactéries, qu’au contrôle des eaux chargées en flore interférente.
COMPASS® cc Agar est certifié par AFNOR Certification sous Attestation N° BKR 23/08-06/12 pour le dénombrement des Escherichia coli et des coliformes dans les eaux de consommation humaine en 24 ± 3 heures.
Disponible en milieu de base déshydraté : Flacon de 500 g (à utiliser avec le supplément sélectif pour COMPASS® cc Agar BS08408).
Disponible aussi en milieu prêt-à-l’emploi : 20 boîtes de Petri Ø 55 mm (BM15308)
En vertu des exigences réglementaires, un permis de l'USDA (VS 16-3) est obligatoire pour les expéditions du Canada vers les États-Unis en raison de l'inclusion de peptone, un sous-produit animal.
COMPASS® cc Agar est certifié NF VALIDATION pour le dénombrement des Escherichia coli et des coliformes dans les eaux de consommation humaine en 24 ± 3 heures, par rapport à la méthode de référence NF EN ISO 9308- 1 :2000. Se référer au certificat disponible sur le site NF VALIDATION pour la date de fin de validité de la méthode. Dans le cadre de la marque NF Validation, se référer à la norme ISO 8199 :2018 pour la préparation des milieux et les dénombrements.
La présence simultanée de deux substrats chromogènes permet la détection des deux activités enzymatiques spécifiques : la β-galactosidase et la β-glucuronidase. Les bactéries appartenant au groupe des coliformes se distinguent par la production d’une β-galactosidase (β-gal). Cette enzyme réagit avec le mélange chromogène pour former un précipité de couleur rose.
Toutes les souches d’ Escherichia coli possèdent une β-galactosidase et 94 à 97% d’entre elles possèdent également une β-glucuronidase (GUD). La présence de cette enzyme est révélée par la présence d’un composé de couleur bleue. L’action simultanée des deux enzymes fait apparaître les colonies d’Escherichia coli en bleu violet. Du fait du principe utilisé, la méthode met en évidence les bactéries lactose négative mais β-galactosidase positive.
| Microorganismes | Phénotype typique | Coloration des colonies |
|---|---|---|
| Escherichia coli | GUD + / β-gal + | bleue violette |
| Coliformes non Escherichia coli | GUD - / β-gal + | rose |
| Autres bactéries à Gram négatif | GUD - / β-gal - | blanche |
Le mélange spécial de peptones favorise l’excellente croissance des coliformes et le système sélectif permet d’inhiber les espèces potentiellement interférentes. Le système tampon permet de se placer dans les conditions optimales des réactions enzymatiques
Produits connexes
Supplément sélectif pour COMPASS® CC Agar